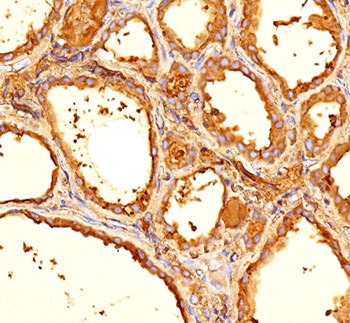
TG Antibody / Thyroglobulin

You have no items in your shopping cart.
TG Antibody / Thyroglobulin
Catalog Number: orb606454
| Catalog Number | orb606454 |
|---|---|
| Category | Antibodies |
| Description | MAb r2H11 reacts with a partially defined epitope of human thyroglobulin. This epitope is different form the epitope recognized by MAb 6E1. Thyroglobulin is a 660kDa dimeric pre-protein with mutiple glycosylation sites. It is produced by and processed within the thyroid gland to produce the hormone thyroxine and triiodothyronine. Prior to forming dimers, thyroglobulin monomers undergo conformational maturation in the endoplasmic reticulation. The vast majority of follicular carcinomas of the thyroid will give positive immunoreactivity for anti-thyroglobulin even though sometimes only focally. Poorly differentiated carcinomas of the thyroid are frequently anti-thyroglobulin negative. Adenocarcinomas of other-than-thyroid origin do not react with this antibody. This antibody is useful in identification of thyroid carcinoma of the papillary and follicular types. Presence of thyroglobulin in metastatic lesions establishes the thyroid origin of tumor. Anti-thyroglobulin, combined with anti-calcitonin, can identify medullary carcinomas of the thyroid. Furthermore, anti-thyroglobulin, combined with anti-TTF1, can be a reliable marker to differentiate between primary thyroid and lung neoplasms. |
| Clonality | Recombinant |
| Species/Host | Mouse |
| Isotype | Mouse IgG1, kappa |
| Conjugation | Unconjugated |
| Reactivity | Human, Mouse, Rat |
| Immunogen | Human thyroid follicular cells were used as the immunogen for the recombinant Thyroglobulin antibody. The epitope recognized by mAb r2H11 is different than that recognized by mAb 6E1/r6E1. |
| UniProt ID | P01266 |
| Tested applications | IHC-P |
| Dilution range | Immunohistochemistry (FFPE): 0.1-0.2ug/ml for 30 min at RT |
| Application notes | Optimal dilution of the recombinant Thyroglobulin antibody should be determined by the researcher.1. The prediluted format is supplied in a dropper bottle and is optimized for use in IHC. After epitope retrieval step (if required), drip mAb solution onto the tissue section and incubate at RT for 30 min. |
| Antibody Type | Primary Antibody |
| Clone Number | r2H11 |
| Formula | 0.2 mg/ml in 1X PBS with 0.1 mg/ml BSA (US sourced) and 0.05% sodium azide |
| Storage | Maintain refrigerated at 2-8°C for up to 2 weeks. For long term storage store at -20°C in small aliquots to prevent freeze-thaw cycles. |
| Research Area | Epigenetics |
| Note | For research use only |

IHC: Formalin-fixed, paraffin-embedded human thyroid gland stained with recombinant Thyroglobulin antibody (clone r2H11). Required HIER: boil tissue sections in pH9 10mM Tris with 1mM EDTA for 10-20 min followed by cooling at RT for 20 min.

IHC: Formalin-fixed, paraffin-embedded human thyroid gland stained with recombinant Thyroglobulin antibody (clone r2H11). Required HIER: boil tissue sections in pH9 10mM Tris with 1mM EDTA for 10-20 min followed by cooling at RT for 20 min.

SDS-PAGE analysis of purified, BSA-free recombinant Thyroglobulin antibody (clone r2H11) as confirmation of integrity and purity.
TG Antibody / Thyroglobulin [orb248557]
ELISA, IHC-P
Human, Mouse, Rat
Mouse
Monoclonal
Unconjugated
20 μg, 100 μg
TG Antibody / Thyroglobulin (orb606454)
Participating in our Biorbyt product reviews program enables you to support fellow scientists by sharing your firsthand experience with our products.
Login to Submit a Review